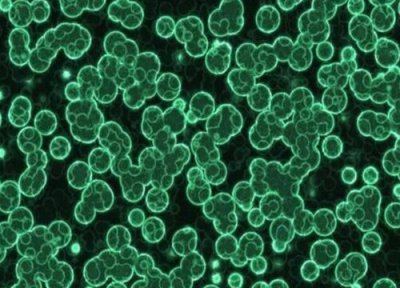
蓝细菌是植物吗 属于原核细菌

用青苔种兰花怎么施肥 有青苔的盆栽兰花怎么施肥
如果想了解用青苔种兰花怎么施肥的内容,接下来「常识社」小编为大家介绍。

有兰友提问:用青苔种兰花怎么施肥?
其实,你所说的“青苔”,就是指“泥炭藓”,也就是我们常说的“苔藓”植物,主要是由其叶和茎组成的。
而采用苔藓养兰时,由于其营养成分不足,需要给予氮、磷、钾三种元素的及时补充,才能满足兰花在生长发育过程中的养分需求。
因此,要回答好你的这个问题,首先就要弄清,采用苔藓养兰的园艺价值和它的主要成分含量。

从利用苔藓来栽培兰花的园艺价值上看,主要体现在:
利用它具有空腔薄壁细胞来吸收并传送水分,空腔细胞中含有水分和空气,使得兰根所吸收的水分和氧气,能够及时地输送到兰花的假鳞茎和叶片等各个部位。
由于苔藓这种植物,还具有木质化的细胞壁,这就使得干燥后的空腔细胞被空气填充满。在形状结构上不会坍塌,因此即使变成了泥炭后仍然能吸收和输送水分。

兰花生长在苔藓中,只要保持水分合适,就能提供给兰花生长所需的理想湿度和空气含量。
尽管如此,苔藓本身也因营养物质少,吸收、储存、输送给兰花各个部位的营养物质匮乏,需要追施肥料来加以补充。
如追施长效颗粒缓释肥料“魔肥”,可以在盆面散放20~30粒即可。
由于颗粒状魔肥不易在浇水或下雨时被溶化,待兰花需要养分时,它才释放出磷、镁元素,能够维持兰花长效持续的养分供给。

而尿素和磷酸二氢钾等无机肥,则应稀释1000~2000倍后再使用。无机肥料所含有的养分不同,对兰花的功效也是不同的。
因此,应配合施用,喷叶面肥和灌根肥交替进行,在兰花营养生长期,以追施氮肥为主,磷钾肥为辅;在生殖生长前期,则应追施磷钾肥为主。
在施肥的间方面,我们一般可以隔期应以10~15天追施一次为宜,每月连续施用2~3次即可。
上述就是有青苔的盆栽兰花怎么施肥 及其 用青苔种兰花怎么施肥的生活小经验,希望能为您在生活中带来帮助!
相关阅读
-
对红是否怕冻 对红冬天怎么养护
冬天养对红需要及时的采取保暖措施,最好是将其搬到室内进行养护,还可以放在室内有阳光照射的地方,保证有适量的光照,利于过冬。另外,对红冬季养护还要注意合理浇水,因为冬天是
-
大葱的软腐病要怎样防治 大葱软腐病症状病因及防治方法
本文分享的大葱的软腐病要怎样防治 大葱软腐病症状病因及防治方法的全部内容,您了解了吗? 大葱软腐病的症状表现 大葱软腐病属于细菌性病害,大多发生在大葱生育中后期,主要危害大
-
莲花和荷花是同一种花吗 莲花和荷花是两种不同的花卉
『常识社』网为你介绍莲花和荷花是同一种花吗的生活小知识,具体内容如下: 莲花和荷花为什么不同,有区别吗? 莲花和荷花是两种不同的花卉,它们在外貌和特征上有明显的区别。 在中
-
蓝莓怎么留种子 种子繁殖时间与方法
对于大多数女性来说蓝莓怎么留种子方面的经验,一起跟随小编看看具体内容吧! 蓝莓留种子方法 蓝莓又叫做笃斯、黑豆树、都柿等,它的种子长在球型的果实之中,花后的70-90天后就会有种